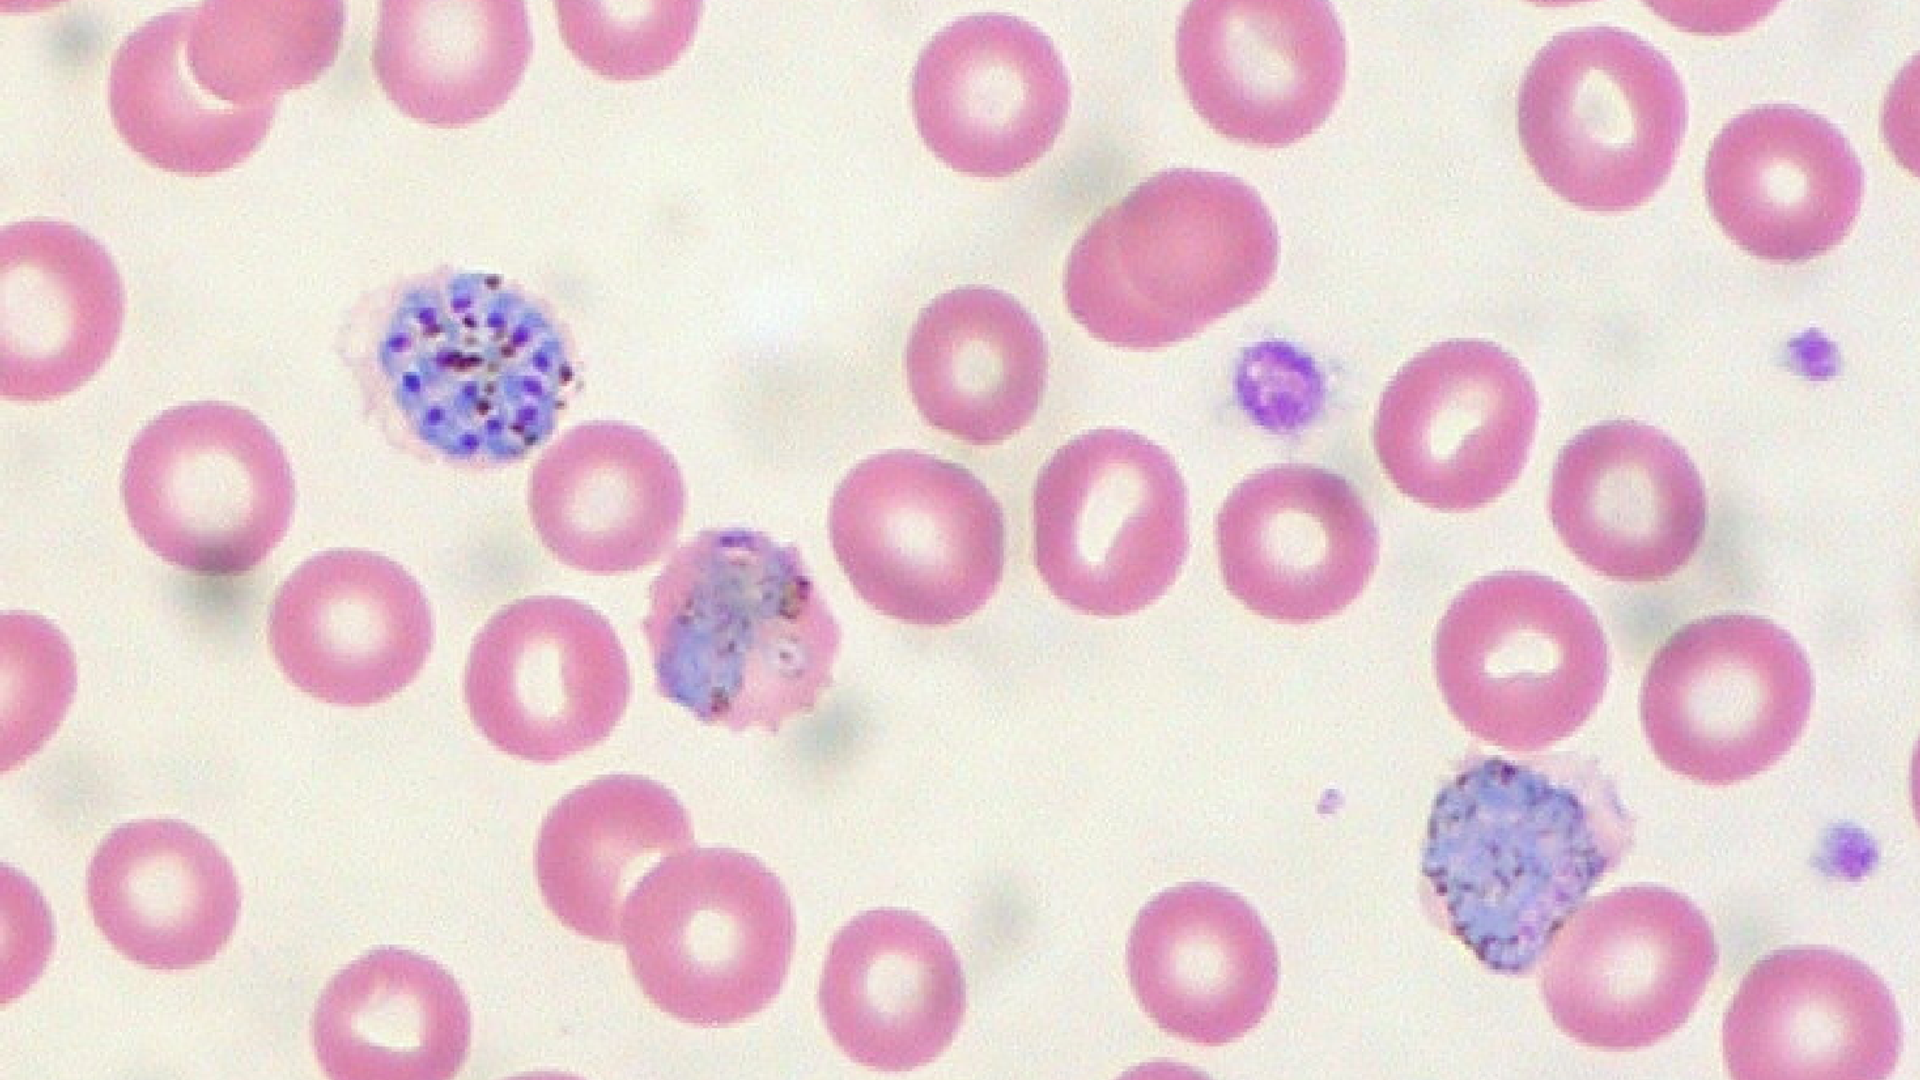

https://noticiaslatam.lat/20211214/aprueban-acuerdo-entre-honduras-y-nicaragua-para-combate-a-la-malaria-1119285663.html
Aprueban un acuerdo entre Honduras y Nicaragua para combatir la malaria
Aprueban un acuerdo entre Honduras y Nicaragua para combatir la malaria
Sputnik Mundo
MANAGUA (Sputnik) — Los gobiernos de Honduras y Nicaragua podrán implementar acciones conjuntas en la frontera común de 940 kilómetros de longitud, para... 14.12.2021, Sputnik Mundo
2021-12-14T03:10+0000
2021-12-14T03:10+0000
2021-12-14T03:26+0000
américa latina
nicaragua
honduras
centroamérica
malaria
https://cdn.img.noticiaslatam.lat/img/106610/70/1066107045_0:88:1469:914_1920x0_80_0_0_138e89bb6088f827eda00a293d2c1e08.png
El acuerdo permitirá a las autoridades de salud de ambos países realizar acciones conjuntas a ambos lados de la frontera, garantizar medicamentos para el tratamiento de personas enfermas y pruebas de diagnóstico, complementariedad de la atención y compartir la información sobre la propagación o eliminación de la enfermedad.El Mapa de la Salud de Nicaragua ubica a la malaria provocada por el parásito Plasmodium vivax, como la primera enfermedad epidémica de 2020, que aunque no provocó fallecidos, sí enfermó a 12.932 personas.La segunda enfermedad epidémica durante el año pasado, de acuerdo al Ministerio de Salud (Minsa) de Nicaragua, es la malaria provocada por el parásito falciparum, que lo transmite el zancudo anófeles y provocó 11.010 enfermos principalmente en comunidades del Caribe norte y en la frontera con Honduras.El acuerdo binacional entre Honduras y Nicaragua para el combate a la malaria espera tener como resultado el avance de la eliminación de la enfermedad en la región centroamericana, evitar su reintroducción y su restablecimiento en los estados miembros del Sistema de Integración Centroamericana y Mesoamérica.Datos de la Organización Mundial de la Salud de 2020, indican que 241 millones de personas contrajeron la malaria, de las cuales 627.000 fallecieron por la enfermedad, lo que representa 14 millones más de los casos positivos registrados en 2019 y un incremento de 69.000 muertes en comparación con el año anterior.
https://noticiaslatam.lat/20211009/la-oms-aprueba-la-primera-vacuna-contra-la-malaria-un-momento-historico-1116937773.html
nicaragua
honduras
centroamérica
Sputnik Mundo
contacto@sputniknews.com
+74956456601
MIA „Rossiya Segodnya“
2021
Sputnik Mundo
contacto@sputniknews.com
+74956456601
MIA „Rossiya Segodnya“
Noticias
es_ES
Sputnik Mundo
contacto@sputniknews.com
+74956456601
MIA „Rossiya Segodnya“
Sputnik Mundo
contacto@sputniknews.com
+74956456601
MIA „Rossiya Segodnya“
nicaragua, honduras, centroamérica, malaria
nicaragua, honduras, centroamérica, malaria
Aprueban un acuerdo entre Honduras y Nicaragua para combatir la malaria
03:10 GMT 14.12.2021 (actualizado: 03:26 GMT 14.12.2021) MANAGUA (Sputnik) — Los gobiernos de Honduras y Nicaragua podrán implementar acciones conjuntas en la frontera común de 940 kilómetros de longitud, para avanzar en la eliminación de la malaria en ambas naciones basado en el derecho comunitario, tras la aprobación de un acuerdo binacional en la Asamblea Nacional de Nicaragua.
"El acuerdo binacional está dentro del contexto del acuerdo de salud que (establece) que todo el mundo debe tener salud como un derecho, todos estamos comprometidos en la salud universal y dos aspectos son importantes: la accesibilidad al servicio y la cobertura", afirmó la diputada Argentina Parajón, presidenta de la Comisión de Salud del Parlamento.
El acuerdo permitirá a las autoridades de salud de ambos países realizar acciones conjuntas a ambos lados de la frontera, garantizar medicamentos para el tratamiento de personas enfermas y pruebas de diagnóstico, complementariedad de la atención y compartir la información sobre la propagación o eliminación de la enfermedad.
El Mapa de la Salud de Nicaragua ubica a la malaria provocada por el parásito Plasmodium vivax, como la primera enfermedad epidémica de 2020, que aunque no provocó fallecidos, sí enfermó a 12.932 personas.
La segunda enfermedad epidémica durante el año pasado, de acuerdo al Ministerio de Salud (Minsa) de Nicaragua, es la malaria provocada por el parásito falciparum, que lo transmite el zancudo anófeles y provocó 11.010 enfermos principalmente en comunidades del Caribe norte y en la frontera con Honduras.

9 de octubre 2021, 21:20 GMT
El acuerdo binacional entre Honduras y Nicaragua para el combate a la malaria espera tener como resultado el avance de la eliminación de la enfermedad en la región centroamericana, evitar su reintroducción y su restablecimiento en los estados miembros del Sistema de Integración Centroamericana y Mesoamérica.
Datos de la Organización Mundial de la Salud de 2020, indican que 241 millones de personas contrajeron la malaria, de las cuales 627.000 fallecieron por la enfermedad, lo que representa 14 millones más de los casos positivos registrados en 2019 y un incremento de 69.000 muertes en comparación con el año anterior.